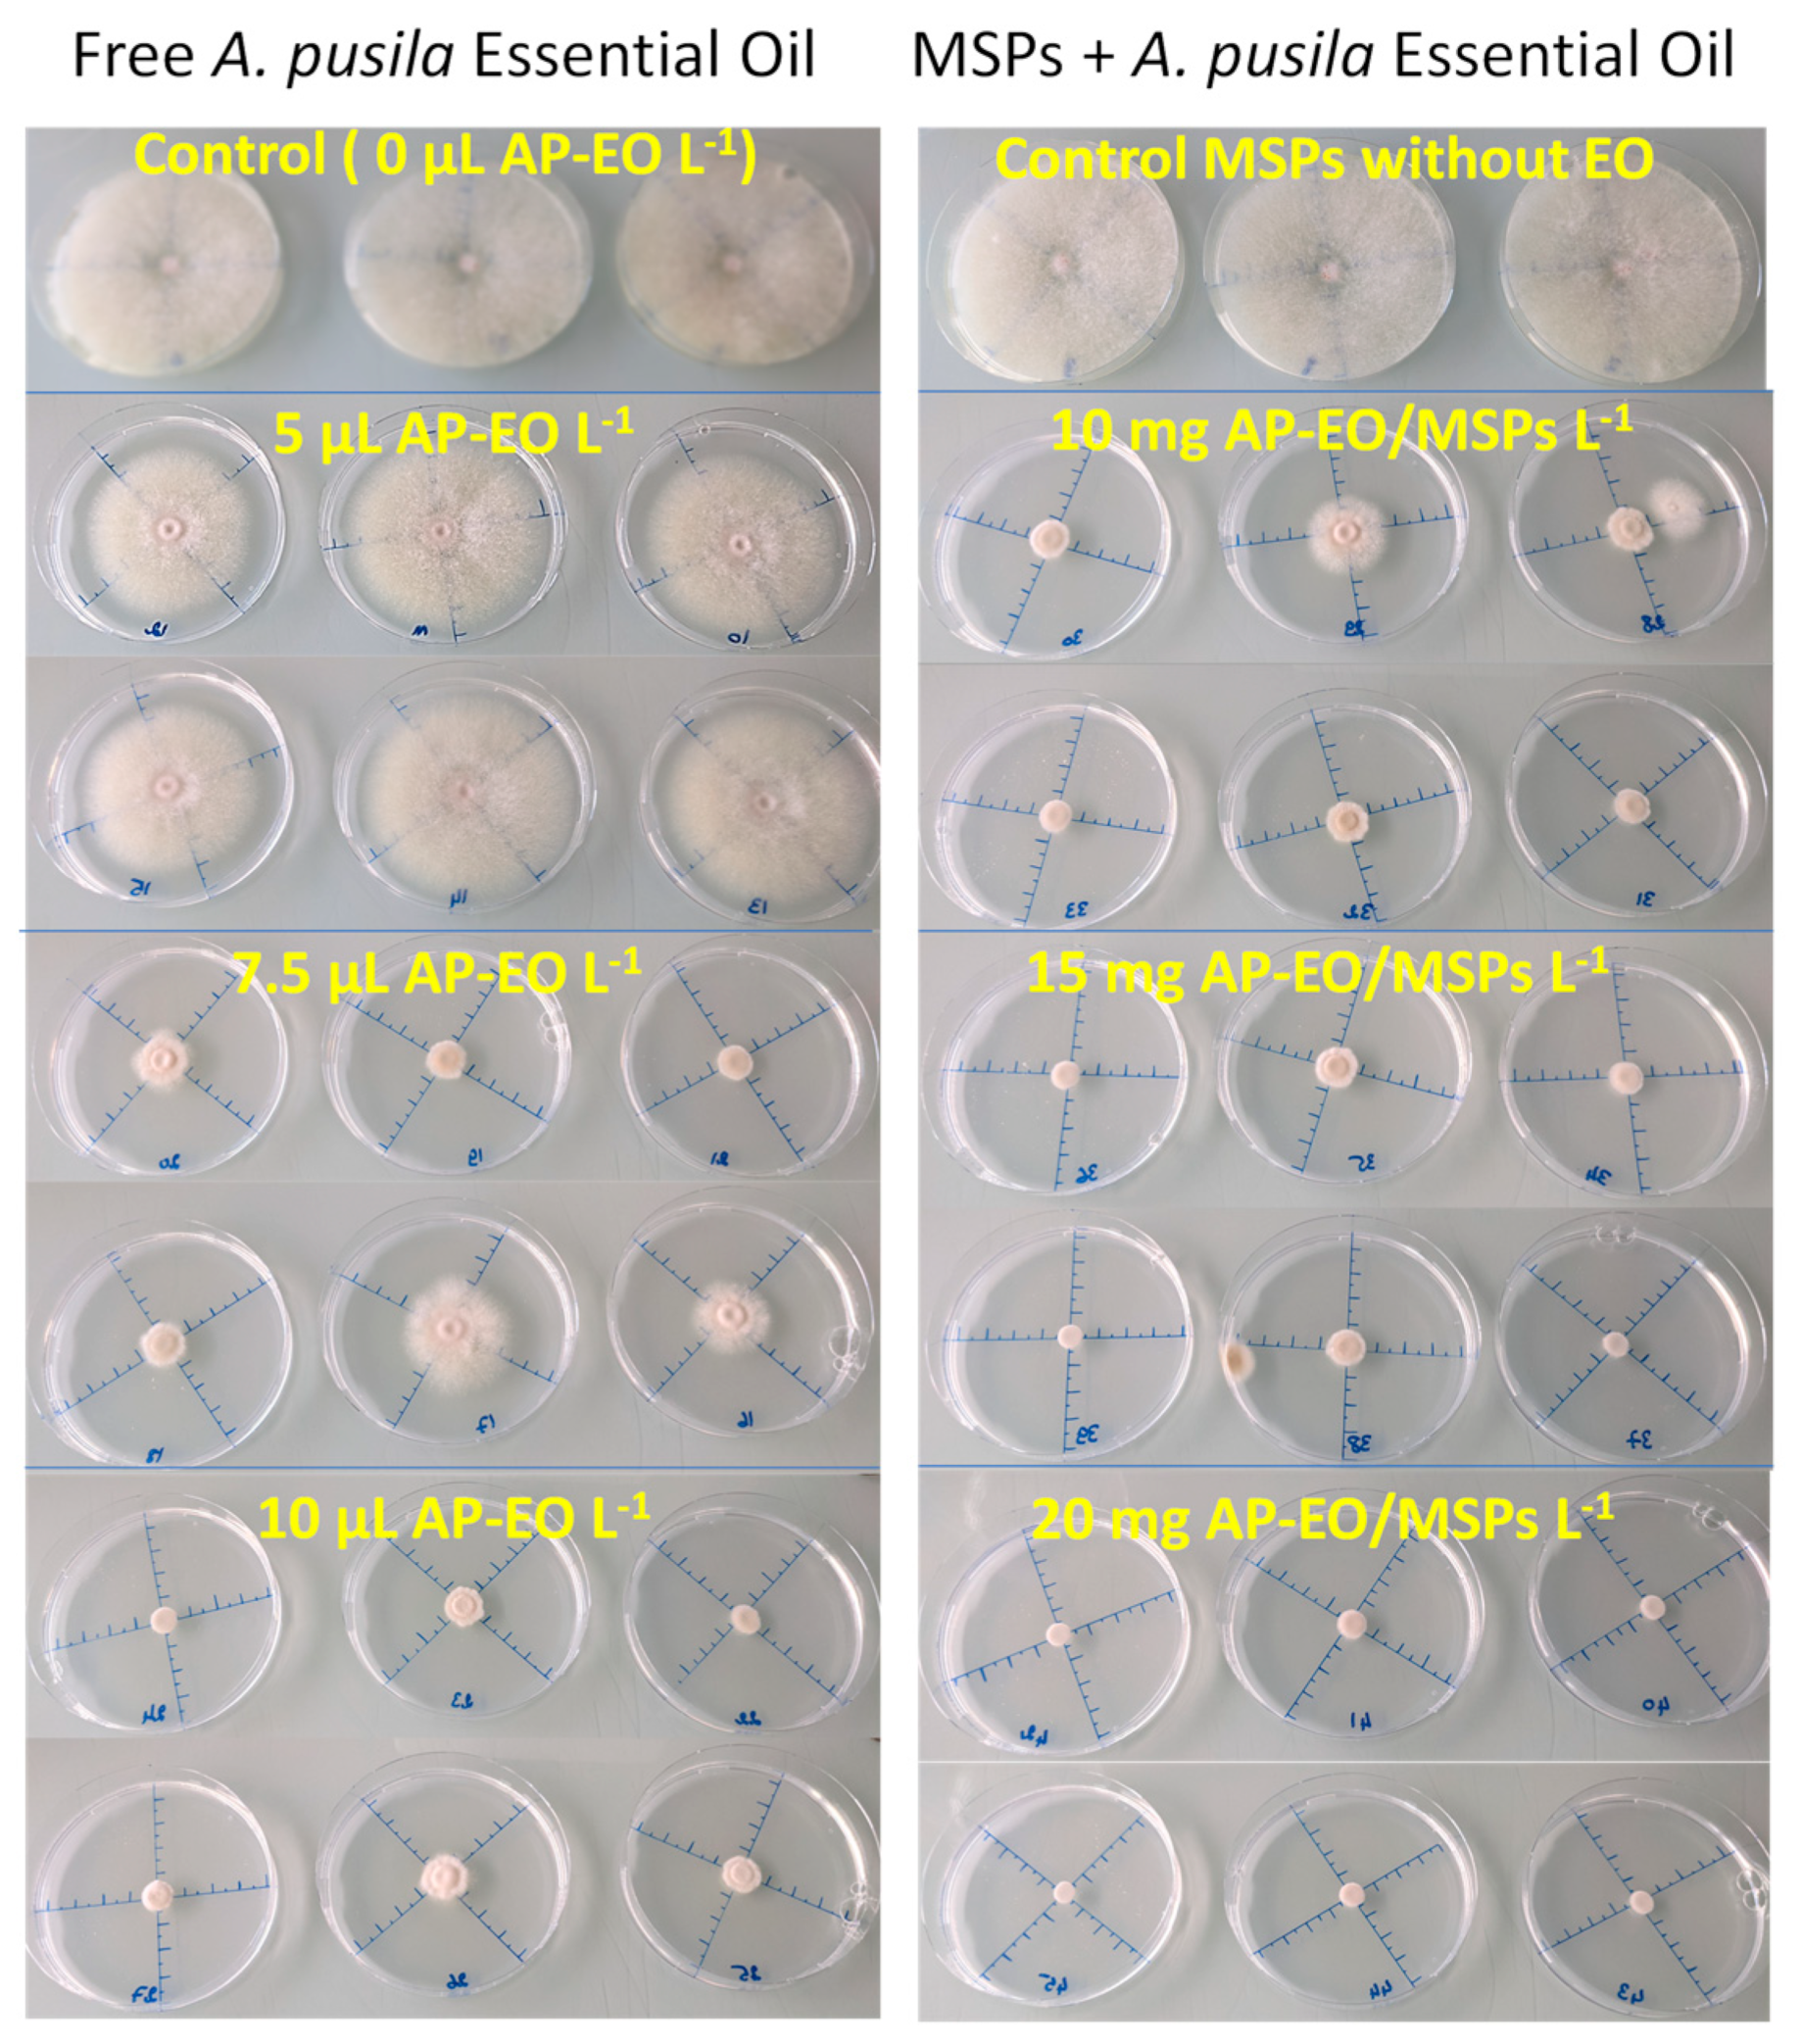
Molecules 28 03194 g010

Encapsulation of Ammoides pusila Essential Oil into Mesoporous Silica Particles for the Enhancement of Their Activity against Fusarium avenaceum and Its Enniatins Production
Abstract
1. Introduction
2. Results
2.1. Mesoporous Silica Nanoparticles Characterization
2.2. Encapsulation Efficiency and EO Release
2.3. Antifungal and Antimycotoxic Activity of the AP-EO Formulations
3. Discussion
3.1. Enhancement of EO Antifungal Activity by Encapsulation in MSPs
3.2. Enhancement of EO Antimycotoxin Activity by Encapsulation in MSPs
3.3. Chitosan Coating of MSPs
4. Materials and Methods
4.1. Mesoporous Silica Particles Synthesis
4.2. Nitrogen Physisorption Measurements at 77K
4.3. XPS
4.4. Thermogravimetric Analysis (TGA)
4.5. Small Angle X-ray Scattering (SAXS)
4.6. Dynamic Light Scattering (DLS)
4.7. Essential Oil Encapsulation and Chitosan Coating
4.8. In Vitro Release of EO in Liquid and Evaporation
4.9. Antifungal Activity of AP-EO Loaded in MSPs against F. avenaceum
4.10. Enniatins Quantification
4.11. Statistical Analysis
5. Conclusions
Author Contributions
Funding
Institutional Review Board Statement
Informed Consent Statement
Data Availability Statement
Acknowledgments
Conflicts of Interest
Sample Availability
References
- Leslie, J.F.; Moretti, A.; Mesterházy, Á.; Ameye, M.; Audenaert, K.; Singh, P.K.; Richard-Forget, F.; Chulze, S.N.; Del Ponte, E.M.; Chala, A.; et al. Key Global Actions for Mycotoxin Management in Wheat and Other Small Grains. Toxins 2021, 13, 725. [Google Scholar] [CrossRef] [PubMed]
- Logrieco, A.; Bottalico, A.; Mulé, G.; Moretti, A.; Perrone, G. Epidemiology of toxigenic fungi and their associated mycotoxins for some Mediterranean crops. In Epidemiology of Mycotoxin Producing Fungi; Xu, X., Bailey, J.A., Cooke, B.M., Eds.; Springer: Dordrecht, The Netherlands, 2003; pp. 645–667. [Google Scholar] [CrossRef]
- Mergoum, M.; Hill, J.P.; Quick, J.S. Evaluation of Resistance of Winter Wheat to Fusarium acuminatum by Inoculation of Seedling Roots with Single, Germinated Macroconidia. Plant Dis. 1998, 82, 300–302. [Google Scholar] [CrossRef] [PubMed]
- Taheri, A.E.; Chatterton, S.; Foroud, N.A.; Gossen, B.D.; McLaren, D.L. Identification and community dynamics of fungi associated with root, crown, and foot rot of field pea in western Canada. Eur. J. Plant Pathol. 2017, 147, 489–500. [Google Scholar] [CrossRef]
- Ederli, L.; Beccari, G.; Tini, F.; Bergamini, I.; Bellezza, I.; Romani, R.; Covarelli, L. Enniatin B and Deoxynivalenol Activity on Bread Wheat and on Fusarium Species Development. Toxins 2021, 13, 728. [Google Scholar] [CrossRef] [PubMed]
- Karlsson, I.; Persson, P.; Friberg, H. Fusarium Head Blight from a Microbiome Perspective. Front. Microbiol. 2021, 12, 628373. [Google Scholar] [CrossRef]
- Proctor, R.H.; Moretti, A. Mycotoxin Production in Fusarium According to Contemporary Species Concepts. Annu. Rev. Phytopathol. 2021, 59, 373–402. [Google Scholar] [CrossRef]
- Prosperini, A.; Berrada, H.; Ruiz, M.J.; Caloni, F.; Coccini, T.; Spicer, L.J.; Perego, M.C.; Lafranconi, A. A review of the mycotoxin enniatin B. Front. Public Health 2017, 5, 304. [Google Scholar] [CrossRef]
- Kalagatur, N.K.; Ghosh, O.S.N.; Sundararaj, N.; Mudili, V. Antifungal Activity of Chitosan Nanoparticles Encapsulated with Cymbopogon martinii Essential Oil on Plant Pathogenic Fungi Fusarium graminearum. Front. Pharmacol. 2018, 9, 610. [Google Scholar] [CrossRef] [PubMed]
- Matusinsky, P.; Zouhar, M.; Pavela, R.; Novy, P. Antifungal effect of five essential oils against important pathogenic fungi of cereals. Ind. Crop. Prod. 2015, 67, 208–215. [Google Scholar] [CrossRef]
- Perczak, A.; Gwiazdowska, D.; Marchwińska, K.; Juś, K.; Gwiazdowski, R.; Waśkiewicz, A. Antifungal activity of selected essential oils against Fusarium culmorum and F. graminearum and their secondary metabolites in wheat seeds. Arch. Microbiol. 2019, 201, 1085–1097. [Google Scholar] [CrossRef] [PubMed]
- Velluti, A.; Marín, S.; Gonzalez, P.; Ramos, A.J.; Sanchis, V. Initial screening for inhibitory activity of essential oils on growth of Fusarium verticillioides, F. proliferatum and F. graminearum on maize-based agar media. Food Microbiol. 2004, 21, 649–656. [Google Scholar] [CrossRef]
- Chakroun, Y.; Atanasova, V.; Jallouli, S.; Oueslati, S.; Abderrabba, M.; Savoie, J.-M. Tunisian Thyme essential oil for controlling enniatins producing Fusarium species. J. Int. Sci. Publ. Agric. Food 2021, 9, 221–230. [Google Scholar]
- Chakroun, Y.; Oueslati, S.; Atanasova, V.; Richard-Forget, F.; Abderrabba, M.; Savoie, J.-M. Ammoides pusilla Essential Oil: A Potent Inhibitor of the Growth of Fusarium avenaceum and Its Enniatin Production. Molecules 2021, 26, 6906. [Google Scholar] [CrossRef]
- Prakash, B.; Kedia, A.; Mishra, P.K.; Dubey, N.K. Plant essential oils as food preservatives to control moulds, mycotoxin contamination and oxidative deterioration of agri-food commodities—Potentials and challenges. Food Control 2015, 47, 381–391. [Google Scholar] [CrossRef]
- Chaudhari, A.K.; Singh, V.K.; Das, S.; Dubey, N.K. Nanoencapsulation of essential oils and their bioactive constituents: A novel strategy to control mycotoxin contamination in food system. Food Chem. Toxicol. 2021, 149, 112019. [Google Scholar] [CrossRef] [PubMed]
- Tisserand, R.; Young, R. Essential oil composition. In Essential Oil Safety, 2nd ed.; Churchill Livingstone: London, UK, 2014; pp. 5–22. [Google Scholar] [CrossRef]
- Horky, P.; Skalickova, S.; Baholet, D.; Skladanka, J. Nanoparticles as a Solution for Eliminating the Risk of Mycotoxins. Nanomaterials 2018, 8, 727. [Google Scholar] [CrossRef]
- Balaure, P.C.; Boarca, B.; Popescu, R.C.; Savu, D.; Trusca, R.; Vasile, B.S.; Grumezescu, A.M.; Holban, A.M.; Bolocan, A.; Andronescu, E. Bioactive mesoporous silica nanostructures with anti-microbial and anti-biofilm properties. Int. J. Pharm. 2017, 531, 35–46. [Google Scholar] [CrossRef]
- Slowing, I.I.; Vivero-Escoto, J.L.; Trewyn, B.G.; Lin, V.S.-Y. Mesoporous silica nanoparticles: Structural design and applications. J. Mater. Chem. 2010, 20, 7924–7937. [Google Scholar] [CrossRef]
- Janatova, A.; Bernardos, A.; Smid, J.; Frankova, A.; Lhotka, M.; Kourimská, L.; Pulkrabek, J.; Kloucek, P. Long-term antifungal activity of volatile essential oil components released from mesoporous silica materials. Ind. Crop. Prod. 2015, 67, 216–220. [Google Scholar] [CrossRef]
- Bernardos, A.; Marina, T.; Žáček, P.; Pérez-Esteve, É.; Martínez-Mañez, R.; Lhotka, M.; Kouřimská, L.; Pulkrábek, J.; Klouček, P. Antifungal effect of essential oil components against Aspergillus niger when loaded into silica mesoporous supports: Antifungal effect of encapsulated essential oils. J. Sci. Food Agric. 2015, 95, 2824–2831. [Google Scholar] [CrossRef]
- Ebadollahi, A.; Sendi, J.J.; Aliakbar, A. Efficacy of Nanoencapsulated Thymus eriocalyx and Thymus kotschyanus Essential Oils by a Mesoporous Material MCM-41 Against Tetranychus urticae (Acari: Tetranychidae). J. Econ. Entomol. 2017, 110, 2413–2420. [Google Scholar] [CrossRef]
- Sattary, M.; Amini, J.; Hallaj, R. Antifungal activity of the lemongrass and clove oil encapsulated in mesoporous silica nanoparticles against wheat’s take-all disease. Pestic. Biochem. Physiol. 2000, 170, 104696. [Google Scholar] [CrossRef]
- Hasheminejad, N.; Khodaiyan, F.; Safari, M. Improving the antifungal activity of clove essential oil encapsulated by chitosan nanoparticles. Food Chem. 2019, 275, 113–122. [Google Scholar] [CrossRef] [PubMed]
- Junca, M.A.V.; Valencia, C.; López, E.F.; Delgado-Ospina, J.; Zapata, P.A.; Solano, M.; Tovar, C.D.G. Chitosan Beads Incorporated with Essential Oil of Thymus capitatus: Stability Studies on Red Tilapia Fillets. Biomolecules 2019, 9, 458. [Google Scholar] [CrossRef] [PubMed]
- Zachetti, V.G.L.; Cendoya, E.; Nichea, M.J.; Chulze, S.N.; Ramirez, M.L. Preliminary Study on the Use of Chitosan as an Eco-Friendly Alternative to Control Fusarium Growth and Mycotoxin Production on Maize and Wheat. Pathogens 2019, 8, 29. [Google Scholar] [CrossRef] [PubMed]
- Das, S.; Singh, V.K.; Dwivedy, A.K.; Chaudhari, A.K.; Deepika; Dubey, N.K. Eugenol loaded chitosan nanoemulsion for food protection and inhibition of Aflatoxin B1 synthesizing genes based on molecular docking. Carbohydr. Polym. 2021, 255, 117339. [Google Scholar] [CrossRef]
- Sing, K.S.W.; Everett, D.H.; Haul, R.A.W.; Moscou, L.; Pierotti, R.A.; Rouquerol, J.; Siemieniewska, T. Reporting physisorption data for gas/solid systems with special reference to the determination of surface area and porosity. Pure Appl. Chem. 1985, 57, 603–619. [Google Scholar] [CrossRef]
- Mohan, A.; Rout, L.; Thomas, A.M.; Peter, J.; Nagappan, S.; Parambadath, S.; Ha, C.-S. Palladium nanoparticles-anchored dual-responsive SBA-15-PNIPAM/PMAA nanoreactor: A novel heterogeneous catalyst for a green Suzuki–Miyaura cross-coupling reaction. RSC Adv. 2020, 10, 28193–28204. [Google Scholar] [CrossRef] [PubMed]
- Hasan, M.; Messaoud, G.B.; Michaux, F.; Tamayol, A.; Kahn, C.J.F.; Belhaj, N.; Linder, M.; Arab-Tehrany, E. Chitosan-coated liposomes encapsulating curcumin: Study of lipid–polysaccharide interactions and nanovesicle behavior. RSC Adv. 2016, 6, 45290–45304. [Google Scholar] [CrossRef]
- Saad, A.; Jlassi, K.; Abderrabba, M.; Chehimi, M.M. Dimethoxytriazine-Triazole Linked Mesoporous Silica Hybrid Sorbent for Cationic Dyes Adsorption. Chem. Afr. 2023, 6, 191–203. [Google Scholar] [CrossRef]
- Jestoi, M. Emerging Fusarium-Mycotoxins Fusaproliferin, Beauvericin, Enniatins, And Moniliformin—A Review. Crit. Rev. Food Sci. Nutr. 2008, 48, 21–49. [Google Scholar] [CrossRef] [PubMed]
- Gautier, C.; Pinson-Gadais, L.; Richard-Forget, F. Fusarium Mycotoxins Enniatins: An Updated Review of Their Occurrence, the Producing Fusarium Species, and the Abiotic Determinants of Their Accumulation in Crop Harvests. J. Agric. Food Chem. 2020, 68, 4788–4798. [Google Scholar] [CrossRef]
- Hanana, M.; Mansour, M.B.; Algabr, M.; Amri, I.; Gargouri, S.; Romane, A.; Jamoussi, B.; Hamrouni, L. Potential use of essential oils from four tunisian species of Lamiaceae: Biological alternative for fungal and weed control. Rec. Nat. Prod. 2017, 11, 258–269. [Google Scholar]
- Sharma, M.; Jain, P.; Mishra, A.; Mehta, A.; Choudhury, D.; Hazra, S.; Basu, S. Variation of surface area of silica monoliths by controlling ionic character/chain length of surfactants and polymers. Mater. Lett. 2017, 194, 213–216. [Google Scholar] [CrossRef]
- Jobdeedamrong, A.; Jenjob, R.; Crespy, D. Encapsulation and Release of Essential Oils in Functional Silica Nanocontainers. Langmuir 2018, 34, 13235–13243. [Google Scholar] [CrossRef]
- Sun, D.; Hussain, H.I.; Yi, Z.; Rookes, J.E.; Kong, L.; Cahill, D.M. Mesoporous silica nanoparticles enhance seedling growth and photosynthesis in wheat and lupin. Chemosphere 2016, 152, 81–91. [Google Scholar] [CrossRef] [PubMed]
- Suriyaprabha, R.; Karunakaran, G.; Yuvakkumar, R.; Prabu, P.; Rajendran, V.; Kannan, N. Growth and physiological responses of maize (Zea mays L.) to porous silica nanoparticles in soil. J. Nanopart. Res. 2012, 14, 1294. [Google Scholar] [CrossRef]
- Suriyaprabha, R.; Karunakaran, G.; Kavitha, K.; Yuvakkumar, R.; Rajendran, V.; Kannan, N. Application of silica nanoparticles in maize to enhance fungal resistance. IET Nanobiotechnol. 2014, 8, 133–137. [Google Scholar] [CrossRef] [PubMed]
- Sun, D.; Hussain, H.I.; Yi, Z.; Siegele, R.; Cresswell, T.; Kong, L.; Cahill, D.M. Uptake and cellular distribution, in four plant species, of fluorescently labeled mesoporous silica nanoparticles. Plant Cell Rep. 2014, 33, 1389–1402. [Google Scholar] [CrossRef] [PubMed]
- Mukarram, M.; Petrik, P.; Mushtaq, Z.; Khan, M.M.A.; Gulfishan, M.; Lux, A. Silicon nanoparticles in higher plants: Uptake, action, stress tolerance, and crosstalk with phytohormones, antioxidants, and other signalling molecules. Environ. Pollut. 2022, 310, 119855. [Google Scholar] [CrossRef] [PubMed]
- Atanasova-Penichon, V.; Barreau, C.; Richard-Forget, F. Antioxidant Secondary Metabolites in Cereals: Potential Involvement in Resistance to Fusarium and Mycotoxin Accumulation. Front. Microbiol. 2016, 7, 566. [Google Scholar] [CrossRef]
- Elieh-Ali-Komi, D.; Hamblin, M.R. Chitin andchitosan: Production and application of versatile biomedical nanomaterials. Int. J. Adv. Res. 2016, 4, 411–427. [Google Scholar]
- Beyki, M.; Zhaveh, S.; Khalili, S.T.; Rahmani-Cherati, T.; Abollahi, A.; Bayat, M.; Tabatabaei, M.; Mohsenifar, A. Encapsulation of Mentha piperita essential oils in chitosan–cinnamic acid nanogel with enhanced antimicrobial activity against Aspergillus flavus. Ind. Crop. Prod. 2014, 54, 310–319. [Google Scholar] [CrossRef]
- López-Meneses, A.; Plascencia-Jatomea, M.; Lizardi-Mendoza, J.; Fernández-Quiroz, D.; Rodríguez-Félix, F.; Mouriño-Pérez, R.; Cortez-Rocha, M. Schinus molle L. essential oil-loaded chitosan nanoparticles: Preparation, characterization, antifungal and anti-aflatoxigenic properties. LWT 2018, 96, 597–603. [Google Scholar] [CrossRef]
- Wan, J.; Zhong, S.; Schwarz, P.; Chen, B.; Rao, J. Physical properties, antifungal and mycotoxin inhibitory activities of five essential oil nanoemulsions: Impact of oil compositions and processing parameters. Food Chem. 2019, 291, 199–206. [Google Scholar] [CrossRef] [PubMed]
- Kujur, A.; Kumar, A.; Yadav, A.; Prakash, B. Antifungal and aflatoxin B1 inhibitory efficacy of nanoencapsulated Pelargonium graveolens L. essential oil and its mode of action. LWT 2020, 130, 109619. [Google Scholar] [CrossRef]
- Purwanto, E.; Connor, J.; Ngothai, Y. The kinetics oxidative degradation of chitosan in formic acid with the presence of hydrogen peroxide. IOP Conf. Ser. Mater. Sci. Eng. 2019, 703, 012041. [Google Scholar] [CrossRef]
- Savitri, E.; Juliastuti, S.R.; Handaratri, A.; Roesyadi, A. Degradation of chitosan by sonication in very-low-concentration acetic acid. Polym. Degrad. Stab. 2014, 110, 344–352. [Google Scholar] [CrossRef]
- Kou, S.G.; Peters, L.M.; Mucalo, M.R. Chitosan: A review of sources and preparation methods. Int. J. Biol. Macromol. 2021, 169, 85–94. [Google Scholar] [CrossRef]
- Kresge, C.T.; Leonowicz, M.E.; Roth, W.J.; Vartuli, J.C.; Beck, J.S. Ordered mesoporous molecular sieves synthesized by a liquid-crystal template mechanism. Nature 1992, 359, 710–712. [Google Scholar] [CrossRef]
- Brunauer, S.; Emmett, P.H.; Teller, E. Adsorption of gases in multimolecular layers. J. Am. Chem. Soc. 1938, 60, 309–319. [Google Scholar] [CrossRef]
- Barrett, E.P.; Joyner, L.G.; Halenda, P.P. The Determination of Pore Volume and Area Distributions in Porous Substances. I. Computations from Nitrogen Isotherms. J. Am. Chem. Soc. 1951, 73, 373–380. [Google Scholar] [CrossRef]
- Qiu, C.; Chang, R.; Yang, J.; Ge, S.; Xiong, L.; Zhao, M.; Li, M.; Sun, Q. Preparation and characterization of essential oil-loaded starch nanoparticles formed by short glucan chains. Food Chem. 2017, 221, 1426–1433. [Google Scholar] [CrossRef]
- Ahmadi, A.; Sokunbi, M.; Patel, T.; Chang, M.-W.; Ahmad, Z.; Singh, N. Influence of Critical Parameters on Cytotoxicity Induced by Mesoporous Silica Nanoparticles. Nanomaterials 2022, 12, 2016. [Google Scholar] [CrossRef] [PubMed]

Disclaimer/Publisher’s Note: The statements, opinions and data contained in all publications are solely those of the individual author(s) and contributor(s) and not of MDPI and/or the editor(s). MDPI and/or the editor(s) disclaim responsibility for any injury to people or property resulting from any ideas, methods, instructions or products referred to in the content. |
© 2023 by the authors. Licensee MDPI, Basel, Switzerland. This article is an open access article distributed under the terms and conditions of the Creative Commons Attribution (CC BY) license (https://creativecommons.org/licenses/by/4.0/).
Share and Cite
Chakroun, Y.; Snoussi, Y.; Chehimi, M.M.; Abderrabba, M.; Savoie, J.-M.; Oueslati, S. Encapsulation of Ammoides pusila Essential Oil into Mesoporous Silica Particles for the Enhancement of Their Activity against Fusarium avenaceum and Its Enniatins Production. Molecules 2023, 28, 3194. https://doi.org/10.3390/molecules28073194
Chakroun Y, Snoussi Y, Chehimi MM, Abderrabba M, Savoie J-M, Oueslati S. Encapsulation of Ammoides pusila Essential Oil into Mesoporous Silica Particles for the Enhancement of Their Activity against Fusarium avenaceum and Its Enniatins Production. Molecules. 2023; 28(7):3194. https://doi.org/10.3390/molecules28073194
Chicago/Turabian StyleChakroun, Yasmine, Youssef Snoussi, Mohamed M. Chehimi, Manef Abderrabba, Jean-Michel Savoie, and Souheib Oueslati. 2023. "Encapsulation of Ammoides pusila Essential Oil into Mesoporous Silica Particles for the Enhancement of Their Activity against Fusarium avenaceum and Its Enniatins Production" Molecules 28, no. 7: 3194. https://doi.org/10.3390/molecules28073194
APA StyleChakroun, Y., Snoussi, Y., Chehimi, M. M., Abderrabba, M., Savoie, J.-M., & Oueslati, S. (2023). Encapsulation of Ammoides pusila Essential Oil into Mesoporous Silica Particles for the Enhancement of Their Activity against Fusarium avenaceum and Its Enniatins Production. Molecules, 28(7), 3194. https://doi.org/10.3390/molecules28073194

